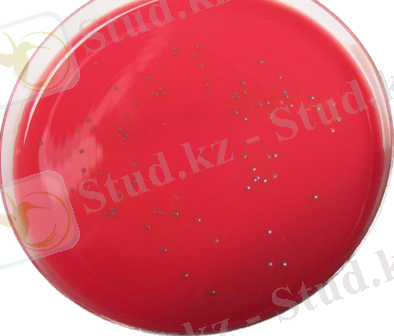
https://upload.wikimedia.org/wikipedia/commons/thumb/b/b1/Smooth_L%27mono-trans.png/394px-Smooth_L%27mono-trans.png

Листериоз: ауыл шаруашылығы жануарларындағы этиологиясы, патогенезі, клиникасы, диагностикасы және алдын алу


І. Кіріспе
Листериоз-Listeria monocytobenes-s шақырылатын, әр түрлі жолымен жұғатын мононуклеарлы фагациттердің зақымдануымен жүретін, жедел тұрде қызбамен, жалпы интоксикациямен өтетін ангиозды, септикалық, жүйелік түрлерінде өтетін зоонозды инфекция.
Лисетриялар көбею үстінде
Этиологиясы.
Қоздырғышы листерия- Vertae monocytodens, 1911ж ашылған. Грамм оң, таяқша тәрізді 0, 5-2х0, 3-5 мкм ширақталған қозғалмалы бактериялар. Әлсіз қышқылды ортада жақсы өседі. Листериозда Н-антиген және О антигені бар. Олар жойылғанда эндотоксин бөледі. Қазіргі күнде листерийлардың 7-і түрі белгілі. Төменгі температураға төзімді, қайнатқан кезде 3-5 минут ішінде өледі. Топырақта, қамыста, лайланған суда бірнеше жылға дейін сақталады. Сүт, ет тағамдарында 4-6С-да өлмейді, керісінше көбейеді. Оларға дезинфекциялық заттар қарсы әсер етеді.
Індеттік ерекшеліктері. Листериозға қой, ешкі, сиыр, шошқа, жылқы, қоян, күзен, тауық, үйрек, қаз, күркетауық бейім. Сонымен қатар, ит, мысық және маймылдың даауыратындығы белгілі болды. Жалпы алғанда листериялар 92 түрлі жабайы жануарлар, одан қала берді иксод жәе гамза кенелері, бит пен бүрге, бөгелектің балапан құртынан да бөлініп алынған. Бұның бәрі листериоздың үй жануарларына жұғуы үшін қауіпті. Әсіресе кемірушілер араында байқалып, оқтын оқтын тышқан тектестерді көп шығынға ұшырататын індет ауыл шаруашылық маалдары үшін аса қауіпті.
Қазақстанда және көршілес елдерде басқа малдармен салыстырғанда негізінен қой ауырады да, бұл түліктің ауруға щалдығуы көрсеткіші де, өлім көрсеткіші де жоғары болады. Басқа елдерде сиырдың ауруы да жиі ұшырайды. Листериозбен жануарлар кез келген жата ауырады, әйтсе де, жас төл мен буаз малдрының бейімділігі жоғары болады.
Қазақстанда қойдың листериозы солтүстік облыстарының орманды және далалы аймақтарында жиі байқалады. Бұған табиғи себептермен қатар қоздырушысы үшін қолайлы орта болып табылатын сүрлемді мал азығын кеңінен пайдалану да әсер етеді. Листериоздың қоздырушысының бастауы- ауырған және аурып жазылған малдар. Олар листериаларды сыртқы ортаға несеп, нәжіс, сүт және көзден, танаудан, жыныс мүшелерінен аққан сорамен бөліп шығарады. Ауырып жазылған жануарлар ұзақ уақыт бойы, қой мен шошқа 30күн, кейбір кесірушілер 260 күнге дейін, листериоздан болған желінсау кезінде сүтпен саулықтар 90, ал сиыр 300күнге дейін сыыртқы ортаға микроб бөліп шығарады. Иксод кенелерінде қоздырушы 500 күнге дейін тіршілігін жоймайды.
Листериоздың ең қауіпті таратушылары және негізгі табиғи қорламасы - тышұан тектес кемірушілер. Олардың бөлінділерімен жайылым, жемшөп, су мен топырақ ластанып, одан барып басқа жануарларға жұғады. Ал ауыл шаруашылық малдары үшін ең басты жұғу жолдары сүрлем болып табылады. Әсіресе, сапасы нашар, қышқылы аз сүрлемде ауаның температурасы төмен, 0градустен біраз ғана жоғары жағдайда листериялар зардаптылығын сақтап, өсіп өне береді.
Листериозға белгілі бір аймақта орын тебу және табиғи ошақтылық тән. Қойда көбінесе қыс пен көктемде кездеседі, ал басқа жануарларда мұндай маусымдылық байқала қоймайды.
Әдетте ауру қоздырушыссы малдың денесіне негізінен ауыз арқылы, соынмен қатар, тыныыс жолдары, көз коньюнктивасы, зақымданған тері арқылы енеді. Қан сорғыш жәндіктер: кене, бүрге, бит, т. б. қатысуымен трансмиссивтік жолмен жұғуы да мүмкін. Көп жағдайда малдардың листериозға шадығуына кемірушілердің арасында таралған індет себепкер болады.
Листериоз табиғи ошақты зоонозды инфекция. Қоздырғыштың резервуары болып кемірушілер болып табылады ( тышқандар, егеуқұйрықтар, су крысалары, қояндар) т. б. Қазіргі күнде листериоз үй малдарының 12-түрінде, жабайы мал хайуандардың 91 түрінде тіркелген. Үй жануарларының: қой, ешкі, шошқа, ат, ит, мысық, тауық, қаз үйректерде байқалады.
Жұғу жолы:
алиментарлы
Aлиментарлы - жануарлардың өнімдерін қолданғанда.
Трансмиссивт
Трансмиссивті жолмен кене және басқада қан сорғыштар арқылы. Аэрогенді жолмен де жұғылады. Жыныс қатынас арқылы адамнан-адамға жұғады, кей кезде анадан балаға жатыр ішілік жұғуы мүмкін.
Патогенезі:
Листериялар асқорыту жолдары, тыныс-алу жолдары, аранның шырышты қабаттары және зақымдалған тері арқылы енеді. Патогенезінде роль ойнайтын факторлар:
- бактеремия
- токсинемия
- аллергиялық
Листериозбен ауырған науқастардың қанында антиденелер сақталады және жасушалық иммунитет сақталады.
Клиникалық көрінісі:
инкубациялық кезеңі 3-4-5 күнге дейін. Төрт клиникалық белгілерін ажыратады: 1. ангинозды-септикалық; 2. жүйкелік 3. (ұрықта және нәрестелерде) 4. көз безділік формасы; Листериозда жедел, жеделдеу, созылмалы және абортивті кезеңдері байқалады. Ең жиі кездесетін түрі ангинозды септикалық түрі - оң.
катаральды
Катаральды симптомдар айқын көрінеді. Сепсистің пайда болуына әкеп соғады. Бұл кезеңде дене қызуы лихорадкамен жүреді 36-39С 15-20 күнге дейін сақталады. Науқастың бетінде гиперемия байқалады, коньюктивит байқалады. Аранда көп мөлшерде сұйықтық, гиперемия және бөбешіктің ісінуі, ақ жағындылар пайда болады. Мойын лимфа түйіндері үлкейеді, бауыр және көкбауыр аздап үлкейеді. Теріде полиморфты бөртпелер байқалады. Шеттері мононуклеарлардың мөлшері көбейеді. Аурудың өршу кезеңінде менингеальды синдромдар байқалады, арқа бұлшық еттерінің регидтілігі, Керниг-Брудзинский симптомдары әлсіз. Уақытында диагностиканы ажыратып ауру толығымен жазылады, кей жағдайларда өлімге әкеледі. Асқынуы эндокардитке әкеледі.
Жүйкелік формасы
Жүйкелік формасы: листериозда менингит, менингоэнцефалит, энцефалит, ми абцессі, перифералық жүйке жүйесі зақымдалады. Ауру жедел басталады, бас ауруы, қайталамалы құсу. Желке бұлшық ет регидтілігі, Керниг-Брудзинский симптомдары оң, гиперстезия, клоникалық тартылыстар, естің бұзылуы, сандырақ, бұлшық еттердің тартылысы байқалады. Менингоэнцефалит кезінде-жоғарыда айтылған симптомдарға қоса ошақты симптомдар қосылады, қабақтың птозы, анизонория, стробизм патогенетикалық рефлекстер, терінің сезімталдығы төмендейді. Психикалық бұзылыстар және параличтер болуы мүмкін. Қанда моноцитоз және лейкоцитоз, гранулоцитоз. Жұлын пункциасында сұйықтың жоғары давменилмен шығады. Құрамында-нейтрофильді гранулоциттер, лимфоциттер байқалады. Аурудың кеш кезінде ликворды ірің байқалады түсі лайлы болады. Листериоз перефериалық нерв жүйесін зақымдағанда парездар және параличтер байқалады. Кей кездерде полирадикулоневрит көтеріледі. Листериоздың жүйелік түрі көбінесе бір айға дейінгі балаларды немесе 40 жастан жоғары адамдарда кездеседі.
Созылмалы түрі
Созылмалы түрі клиникалық көріністерге байқалмайды. Аурудың өршуі қысқа уақытты лихорадкамен, катаральды көріністермен кей-кезде ауру созылмалы пиелонефрит түрінде кездеседі, диспепсиялық бұзылыстар байқалады. Листериоздың осы түрі көбінесе жүкті әйелдерде жиі кездеседі.
Абортивті түрі
Абортивті түрі -листериоздың бұл түрі жедел басталады, листериоздың түрлерімен өтеді, бірақта ауру тез аяқталады.
Диагностикасы.
Бактериологиялық зерттеу мұрын-жұтқыншақтың және аранның, коньюктивтерды айқын іріңді, қан церобральды сұйықтың, лимфа түйіндерінен ашылған пунктат, мелоний, ұрық маңайындағы сұйықтың, бала жолдасынан алынады. Серологиялық зерттеу РА, РНГА және РСК жұп сарысуларды тексереміз. Антиденелердің абсорбциясын кистелиани бойынша тексеру, қосымша биологиялық сынақтар өткізіледі. Қояндарға кератоконьюктивалық сынақ жүргізу арқылы анықтауға болады.
Емі.
... жалғасы- Іс жүргізу
- Автоматтандыру, Техника
- Алғашқы әскери дайындық
- Астрономия
- Ауыл шаруашылығы
- Банк ісі
- Бизнесті бағалау
- Биология
- Бухгалтерлік іс
- Валеология
- Ветеринария
- География
- Геология, Геофизика, Геодезия
- Дін
- Ет, сүт, шарап өнімдері
- Жалпы тарих
- Жер кадастрі, Жылжымайтын мүлік
- Журналистика
- Информатика
- Кеден ісі
- Маркетинг
- Математика, Геометрия
- Медицина
- Мемлекеттік басқару
- Менеджмент
- Мұнай, Газ
- Мұрағат ісі
- Мәдениеттану
- ОБЖ (Основы безопасности жизнедеятельности)
- Педагогика
- Полиграфия
- Психология
- Салық
- Саясаттану
- Сақтандыру
- Сертификаттау, стандарттау
- Социология, Демография
- Спорт
- Статистика
- Тілтану, Филология
- Тарихи тұлғалар
- Тау-кен ісі
- Транспорт
- Туризм
- Физика
- Философия
- Халықаралық қатынастар
- Химия
- Экология, Қоршаған ортаны қорғау
- Экономика
- Экономикалық география
- Электротехника
- Қазақстан тарихы
- Қаржы
- Құрылыс
- Құқық, Криминалистика
- Әдебиет
- Өнер, музыка
- Өнеркәсіп, Өндіріс
Қазақ тілінде жазылған рефераттар, курстық жұмыстар, дипломдық жұмыстар бойынша біздің қор #1 болып табылады.



Ақпарат
Қосымша
Email: info@stud.kz